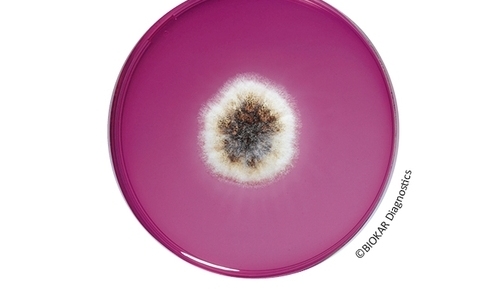

IRIS Salmonella®
IRIS Salmonella® Agar
İnsani tüketim ürünlerinde, hayvan yemlerinde ve çevresel numunede (birincil üretim numuneleri hariç) Salmonella türleri için alternatif bir araştırma yöntemidir. IRIS Salmonnella® Agar üzerinde yapılan çalışmalar, diğer ortamlarda bir karışıklık kaynağı olan atipik türler ve serotipleri dahil Salmonella spp.'nin saptanması için yüksek bir özgüllük göstermektedir. Gerçekten de, Salmonella Typhi ve Paratyphi, laktoz pozitif Salmonella (Salmonella senftenberg ve alt türler S.arizonae ve S.diarizonae), sakkaroz pozitif suşların saptanması sağlanmıştır. Besiyeri, hareketsiz serotiplerin (S.Pullorum ve S.Gallinarum) veya monofazik suşların saptanmasına izin verir. IRIS Salmonella® Agar, diğer ortamda (Salmonella bongori, Salmonella Dublin ve S.Atento, bazı S.enterica suşları, S.houtenae ve S.diarizonae alt türleri) esterasik aktivitenin bir ışığını ya da yokluğunu gösteren suşların saptanmasına izin verir.
ISO 6579 standardı referans alınarak 16140 alternatif metot validasyon standardı kapsamında AFNOR tarafından BKR 23 / 07-10 / 11 referans numarası ile valide edilmiştir.
IRIS Salmonella® Agar, tipik/atipik türler ve serotipleri dahil Salmonella spp.'nin saptanması için yüksek seçiciliğie sahiptir.
Siparişleriniz için:
- BK212HA IRIS Salmonella® Agar - 500g
- BM16008 IRIS Salmonella® Agar - 20x90mm
- BM16108 IRIS Salmonella® Agar - 120x90mm
IRIS Salmonella valide metot Supplementi: